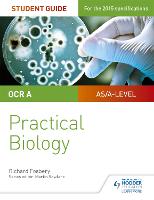

|
|
books
| book details |
OCR A-level Biology Student Guide: Practical Biology
By (author) Richard Fosbery

|
| on special |
normal price: R 429.95
Price: R 386.95
|
| book description |
Exam Board: OCR Level: AS/A-level Subject: Economics First Teaching: September 2015 First Exam: Summer 2016 Ensure your students get to grips with the core practicals and develop the skills needed to succeed with an in-depth assessment-driven approach that builds and reinforces understanding; clear summaries of practical work with sample questions and answers help to improve exam technique in order to achieve higher grades. Written by experienced teacher Martin Rowland, this Student Guide for practical Biology: - Help students easily identify what they need to know with a concise summary of required practical work examined in the A-level specifications. - Consolidate understanding of practical work, methodology, mathematical and other skills out of the laboratory with exam tips and knowledge check questions, with answers in the back of the book. - Provide plenty of opportunities for students to improve exam technique with sample answers, examiners tips and exam-style questions. - Offer support beyond the Student books with coverage of methodologies and generic practical skills not focused on in the textbooks.
| product details |

Normally shipped |
Publisher | Hachette Learning
Published date | 28 Apr 2017
Language |
Format | Paperback / softback
Pages | 104
Dimensions | 246 x 218 x 8mm (L x W x H)
Weight | 231g
ISBN | 978-1-4718-8561-7
Readership Age |
BISAC | science / life sciences / biology / general
| other options |

Normally shipped |
Readership Age |
Normal Price | R 592.95
Price | R 533.95
| on special |
|
|
To view the items in your trolley please sign in.
| sign in |
|
|
|
| specials |
|
|
Mason Coile
Paperback / softback
224 pages
was: R 520.95
now: R 468.95
|
A terrifying locked-room mystery set in a remote outpost on Mars.
|
|
|
An epic love story with the pulse of a thriller that asks: what would you risk for a second chance at first love?
|
|
|
|